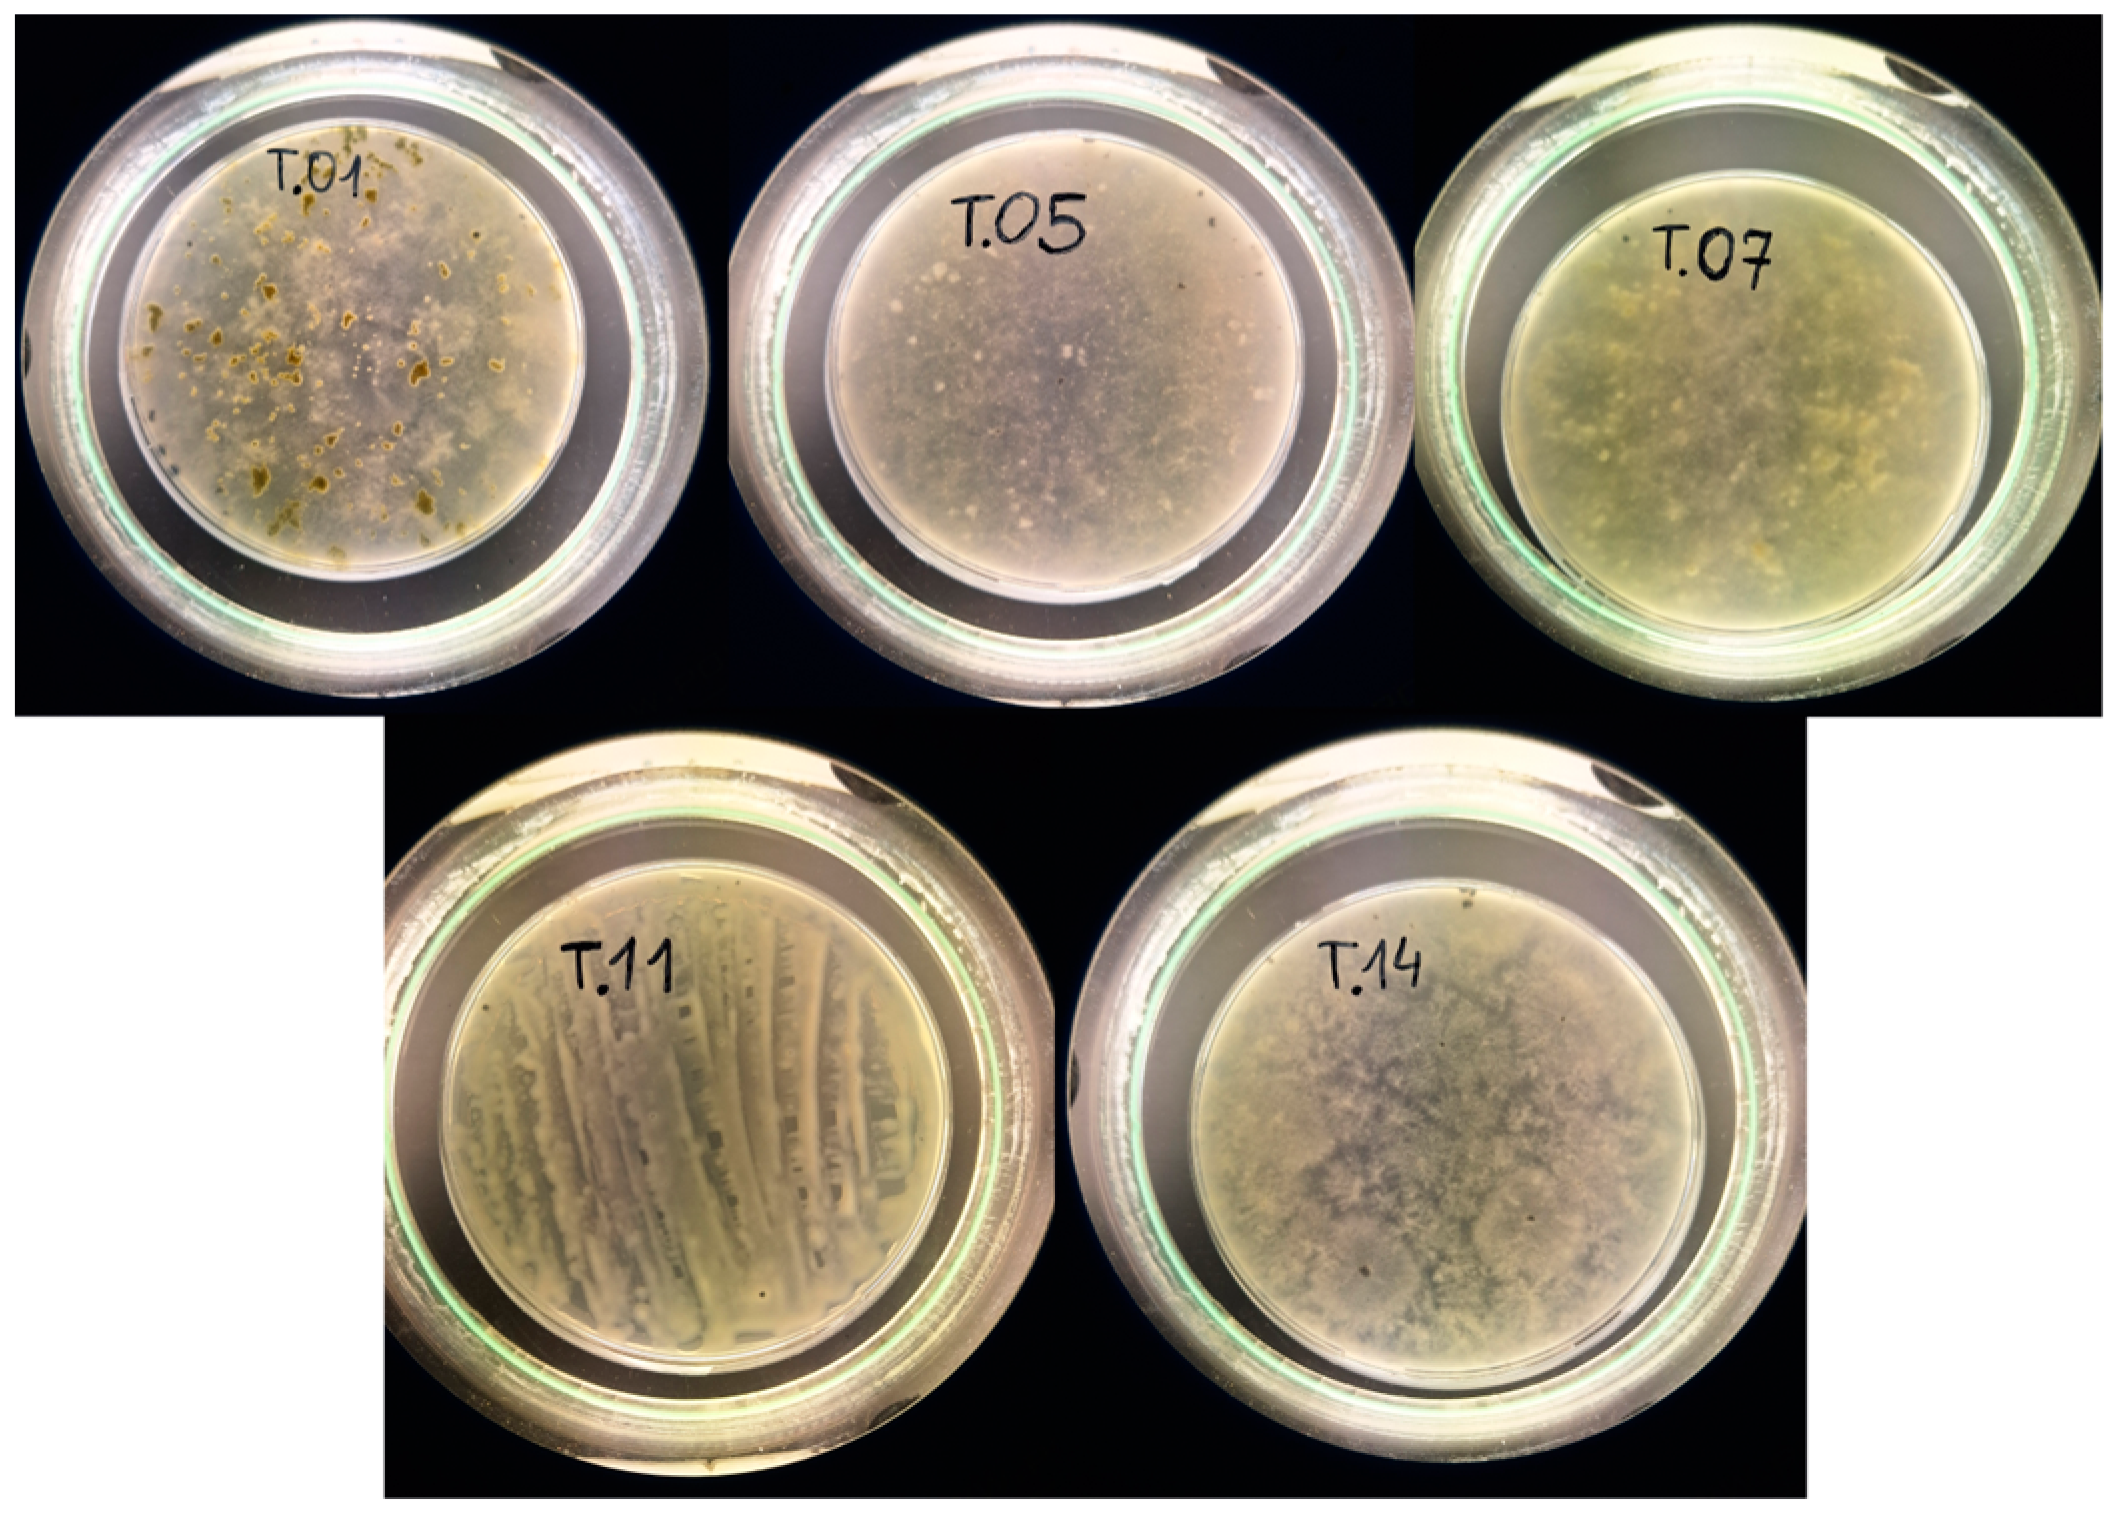
Polymers 16 00574 g001

Biodegradability Study of Modified Chitosan Films with Cinnamic Acid and Ellagic Acid in Soil
Abstract
:1. Introduction
2. Materials and Methods
2.1. Isolation and Molecular Identification of Fungal Strains
2.2. Determination of Enzymatic Activity of Fungi
2.3. Preparation of Chitosan Films
2.3.1. Moisture Content
2.3.2. Biodegradation of Chitosan Films
2.4. Determination of BOD in Soil Containing Modified Chitosan Films after Application of Fungi
2.5. Determination of Enzyme Activity after Application of Fungi to Soil
2.6. Statistical Analysis
3. Results
3.1. Moisture Content
3.2. Enzyme Activity of Isolates from the Soil of the Kampinos Forest
3.3. Respirometric Activity of Fungi (mgO2/L) in the Presence of Modified Chitosan Films
3.4. Biodegradation of Modified Chitosan Film in Soil after Fungal Application
3.5. Changes in Enzyme Activity in Soil after Fungal Application
3.6. Identification of Fungi
4. Discussion
5. Conclusions
Author Contributions
Funding
Institutional Review Board Statement
Informed Consent Statement
Data Availability Statement
Conflicts of Interest
References
- Stubenrauch, J.; Ekardt, F. Plastic Pollution in Soils: Governance Approaches to Foster Soil Health and Closed Nutrient Cycles. Environments 2020, 7, 38. [Google Scholar] [CrossRef]
- Agarwal, S. Biodegradable Polymers: Present Opportunities and Challenges in Providing a Microplastic-Free Environment. Macromol. Chem. Phys. 2020, 221, 2000017. [Google Scholar] [CrossRef]
- Zhang, D.; Ng, E.L.; Hu, W.; Wang, H.; Galaviz, P.; Yang, H.; Sun, W.; Li, C.; Ma, X.; Fu, B.; et al. Plastic Pollution in Croplands Threatens Long-Term Food Security. Glob. Chang. Biol. 2020, 26, 3356–3367. [Google Scholar] [CrossRef] [PubMed]
- Vroman, I.; Tighzert, L. Biodegradable Polymers. Materials 2009, 2, 307–344. [Google Scholar] [CrossRef]
- Prasad, R.D.; Chandrika, K.S.V.P.; Godbole, V. A Novel Chitosan Biopolymer Based Trichoderma Delivery System: Storage Stability, Persistence and Bio Efficacy against Seed and Soil Borne Diseases of Oilseed Crops. Microbiol. Res. 2020, 237, 126487. [Google Scholar] [CrossRef]
- Jaworska, M.; Sakurai, K.; Gaudon, P.; Guibal, E. Influence of Chitosan Characteristics on Polymer Properties. I: Crystallographic Properties. Polym. Int. 2003, 52, 198–205. [Google Scholar] [CrossRef]
- Lertsutthiwong, P.; Noomun, K.; Khunthon, S.; Limpanart, S. Influence of Chitosan Characteristics on the Properties of Biopolymeric Chitosan–Montmorillonite. Nat. Sci. Mater. Int. 2012, 22, 502–508. [Google Scholar] [CrossRef]
- Kaczmarek-Szczepańska, B.; Grabska-Zielińska, S.; Michalska-Sionkowska, M. The Application of Phenolic Acids in The Obtainment of Packaging Materials Based on Polymers—A Review. Foods 2023, 12, 1343. [Google Scholar] [CrossRef]
- Kaczmarek-Szczepańska, B.; Polkowska, I.; Paździor-Czapula, K.; Nowicka, B.; Gierszewska, M.; Michalska-Sionkowska, M.; Otrocka-Domagała, I. Chitosan/Phenolic Compounds Scaffolds for Connective Tissue Regeneration. J. Funct. Biomater. 2023, 14, 69. [Google Scholar] [CrossRef]
- Kaczmarek-Szczepańska, B.; Wekwejt, M.; Mazur, O.; Zasada, L.; Pałubicka, A.; Olewnik-kruszkowska, E. The Physicochemical and Antibacterial Properties of Chitosan- Based Materials Modified with Phenolic Acids Irradiated by Uvc Light. Int. J. Mol. Sci. 2021, 22, 6472. [Google Scholar] [CrossRef]
- Rathore, A.S.; Gupta, R.D. Chitinases from Bacteria to Human: Properties, Applications, and Future Perspectives. Enzyme Res. 2015, 2015, 791907. [Google Scholar] [CrossRef]
- Cycoń, M.; Mrozik, A.; Piotrowska-Seget, Z. Bioaugmentation as a Strategy for the Remediation of Pesticide-Polluted Soil: A Review. Chemosphere 2017, 172, 52–71. [Google Scholar] [CrossRef]
- Priyadarshi, R.; Rhim, J.W. Chitosan-Based Biodegradable Functional Films for Food Packaging Applications. Innov. Food Sci. Emerg. Technol. 2020, 62, 102346. [Google Scholar] [CrossRef]
- Azin, M.; Moravej, R.; Zareh, D. Production of Xylanase by Trichoderma longibrachiatum on a Mixture of Wheat Bran and Wheat Straw: Optimization of Culture Condition by Taguchi Method. Enzyme Microb. Technol. 2007, 40, 801–805. [Google Scholar] [CrossRef]
- Harman, G.E.; Howell, C.R.; Viterbo, A.; Chet, I.; Lorito, M. Trichoderma Species—Opportunistic, Avirulent Plant Symbionts. Nat. Rev. Microbiol. 2004, 2, 43–56. [Google Scholar] [CrossRef] [PubMed]
- Swiontek Brzezinska, M.; Kaczmarek-Szczepańska, B.; Dąbrowska, G.B.; Michalska-Sionkowska, M.; Dembińska, K.; Richert, A.; Pejchalová, M.; Kumar, S.B.; Kalwasińska, A. Application Potential of Trichoderma in the Degradation of Phenolic Acid-Modified Chitosan. Foods 2023, 12, 3669. [Google Scholar] [CrossRef] [PubMed]
- Janczak, K.; Dąbrowska, G.B.; Raszkowska-Kaczor, A.; Kaczor, D.; Hrynkiewicz, K.; Richert, A. Biodegradation of the Plastics PLA and PET in Cultivated Soil with the Participation of Microorganisms and Plants. Int. Biodeterior. Biodegrad. 2020, 155, 105087. [Google Scholar] [CrossRef]
- Janczak, K.; Hrynkiewicz, K.; Znajewska, Z.; Dąbrowska, G. Use of Rhizosphere Microorganisms in the Biodegradation of PLA and PET Polymers in Compost Soil. Int. Biodeterior. Biodegrad. 2018, 130, 65–75. [Google Scholar] [CrossRef]
- Richert, A.; Dąbrowska, G.B. Enzymatic Degradation and Biofilm Formation during Biodegradation of Polylactide and Polycaprolactone Polymers in Various Environments. Int. J. Biol. Macromol. 2021, 176, 226–232. [Google Scholar] [CrossRef]
- Dąbrowska, G.B.; Garstecka, Z.; Olewnik-Kruszkowska, E.; Szczepańska, G.; Ostrowski, M.; Mierek-Adamska, A. Comparative Study of Structural Changes of Polylactide and Poly(Ethylene Terephthalate) in the Presence of Trichoderma viride. Int. J. Mol. Sci. 2021, 22, 3491. [Google Scholar] [CrossRef]
- Ruwizhi, N.; Aderibigbe, B.A. Cinnamic Acid Derivatives and Their Biological Efficacy. Int. J. Mol. Sci. 2020, 21, 5712. [Google Scholar] [CrossRef]
- Ríos, J.L.; Giner, R.M.; Marín, M.; Recio, M.C. A Pharmacological Update of Ellagic Acid. Planta Med. 2018, 84, 1068–1093. [Google Scholar] [CrossRef]
- Kaczmarek-Szczepańska, B.; Sionkowska, M.M.; Mazur, O.; Świątczak, J.; Brzezinska, M.S. The Role of Microorganisms in Biodegradation of Chitosan/Tannic Acid Materials. Int. J. Biol. Macromol. 2021, 184, 584–592. [Google Scholar] [CrossRef]
- Hoppe, H.-G. Significance of Exoenzymatic Activities in the Ecology of Brackish Water: Measurements by Means of Methylumbelliferyl-Substrates. Mar. Ecol. Prog. Ser. 1983, 11, 299–308. [Google Scholar] [CrossRef]
- Freeman, C.; Liska, G.; Ostle, N.J.; Jones, S.E.; Lock, M.A. The use of fluorogenic substrates for measuring enzyme activity in peatlands. Plant Soil 1995, 175, 147–152. [Google Scholar] [CrossRef]
- Niemi, R.M.; Vepsäläinen, M. Stability of the Fluorogenic Enzyme Substrates and PH Optima of Enzyme Activities in Different Finnish Soils. J. Microbiol. Methods 2005, 60, 195–205. [Google Scholar] [CrossRef]
- Rudnik, E.; Briassoulis, D. Comparative Biodegradation in Soil Behaviour of Two Biodegradable Polymers Based on Renewable Resources. J. Polym. Environ. 2011, 19, 18–39. [Google Scholar] [CrossRef]
- Hammer, Ø.; Harper, D.A. Past: Paleontological statistics software package for education and data analysis. Palaeontol. Electron. 2001, 4, 1. [Google Scholar]
- Bravin, B.; Peressini, D.; Sensidoni, A. Development and Application of Polysaccharide-Lipid Edible Coating to Extend Shelf-Life of Dry Bakery Products. J. Food Eng. 2006, 76, 280–290. [Google Scholar] [CrossRef]
- Famiglietti, M.; Savastano, A.; Gaglione, R.; Arciello, A.; Naviglio, D.; Mariniello, L. Edible Films Made of Dried Olive Leaf Extract and Chitosan: Characterization and Applications. Foods 2022, 11, 2078. [Google Scholar] [CrossRef] [PubMed]
- Tao, W.; Wang, G.; Pei, X.; Sun, W.; Wang, M. Chitosan Oligosaccharide Attenuates Lipopolysaccharide-Induced Intestinal Barrier Dysfunction through Suppressing the Inflammatory Response and Oxidative Stress in Mice. Antioxidants 2022, 11, 1384. [Google Scholar] [CrossRef] [PubMed]
- AL-Fawares, O.; Alshweiat, A.; Al-Khresieh, R.O.; Alzarieni, K.Z.; Rashaid, A.H.B. A Significant Antibiofilm and Antimicrobial Activity of Chitosan-Polyacrylic Acid Nanoparticles against Pathogenic Bacteria. Saudi Pharm. J. 2024, 32, 101918. [Google Scholar] [CrossRef] [PubMed]
- Babar, A.; Singh, V.; Mitra, A. Development of active packaging sheet by chitosan with incorporation of ascorbic acid. Asian Jr. Microbiol. Biotech. Environ. Sc. 2023, 25, 845–850. [Google Scholar] [CrossRef]
- Chen, M.Y.; Alexiev, A.; Mckenzie, V.J. Bacterial Biofilm Thickness and Fungal Inhibitory Bacterial Richness Both Prevent Establishment of the Amphibian Fungal Pathogen Batrachochytrium dendrobatidis. Appl. Environ. Microbiol. 2022, 88, e01604–e01621. [Google Scholar] [CrossRef] [PubMed]
- Xu, K.; Dai, Q.; Dong, K.; Wei, N.; Qin, Z. Double Noncovalent Network Chitosan/Hyperbranched Polyethylenimine/Fe3+ Films with High Toughness and Good Antibacterial Activity. RSC Adv. 2022, 12, 5255–5264. [Google Scholar] [CrossRef] [PubMed]
- Shen, B.; Wang, Y.; Wang, X.; Amal, F.E.; Zhu, L.; Jiang, L. A Cruciform Petal-like (ZIF-8) with Bactericidal Activity against Foodborne Gram-Positive Bacteria for Antibacterial Food Packaging. Int. J. Mol. Sci. 2022, 23, 7510. [Google Scholar] [CrossRef] [PubMed]
- Wojnowska-Baryła, I.; Kulikowska, D.; Bernat, K. Effect of Bio-Based Products on Waste Management. Sustainability 2020, 12, 2088. [Google Scholar] [CrossRef]
- Vilela, C.; Pinto, R.J.B.; Coelho, J.; Domingues, M.R.M.; Daina, S.; Sadocco, P.; Santos, S.A.O.; Freire, C.S.R. Bioactive Chitosan/Ellagic Acid Films with UV-Light Protection for Active Food Packaging. Food Hydrocoll. 2017, 73, 120–128. [Google Scholar] [CrossRef]
- Culas, M.S.; Popovich, D.G.; Rashidinejad, A. Recent Advances in Encapsulation Techniques for Cinnamon Bioactive Compounds: A Review on Stability, Effectiveness, and Potential Applications. Food Biosci. 2023, 57, 103470. [Google Scholar] [CrossRef]
- Jia, S.; Jiang, S.; Chen, Y.; Wei, Y.; Shao, X. Comparison of Inhibitory Effects of Cinnamic Acid, β-Cyclodextrin, L-Cysteine, and Ascorbic Acid on Soluble and Membrane-Bound Polyphenol Oxidase in Peach Fruit. Foods 2022, 12, 167. [Google Scholar] [CrossRef]
- Campanale, C.; Galafassi, S.; Di Pippo, F.; Pojar, I.; Massarelli, C.; Uricchio, V.F. A Critical Review of Biodegradable Plastic Mulch Films in Agriculture: Definitions, Scientific Background and Potential Impacts. Trends Analyt. Chem. 2024, 170, 117391. [Google Scholar] [CrossRef]
- Zeng, D.; Luo, X.; Tu, R. Application of Bioactive Coatings Based on Chitosan for Soybean Seed Protection. Int. J. Carbohydr. Chem. 2012, 2012, 104565. [Google Scholar] [CrossRef]
- Hermosa, R.; Viterbo, A.; Chet, I.; Monte, E. Plant-Beneficial Effects of Trichoderma and of Its Genes. Microbiology 2012, 158, 17–25. [Google Scholar] [CrossRef] [PubMed]
- Carvalho, D.D.C.; Geraldine, A.M.; Junior, M.L.; De Mello, S.C.M. Biological Control of White Mold by Trichoderma harzianum in Common Bean under Field Conditions. Pesqui. Agropecu. Bras. 2015, 50, 1220–1224. [Google Scholar] [CrossRef]
- Abdenaceur, R.; Farida, B.T.; Mourad, D.; Rima, H.; Zahia, O.; Fatma, S.H. Effective Biofertilizer Trichoderma Spp. Isolates with Enzymatic Activity and Metabolites Enhancing Plant Growth. Int. Microbiol. 2022, 25, 817–829. [Google Scholar] [CrossRef]
- Contreras-Cornejo, H.A.; López-Bucio, J.S.; Méndez-Bravo, A.; Macías-Rodríguez, L.; Ramos-Vega, M.; Guevara-García, Á.A.; López-Bucio, J. Mitogen-Activated Protein Kinase 6 and Ethylene and Auxin Signaling Pathways Are Involved in Arabidopsis Root-System Architecture Alterations by Trichoderma atroviride. Mol. Plant Microbe Interact. 2015, 28, 701–710. [Google Scholar] [CrossRef]
- Rautela, A.; Dwivedi, M.; Tewari, A.K.; Kumar, J. Enzymatic Activity and Secondary Metabolite Profile of Trichoderma asperellum in Presence of Chitosan. Indian Phytopathol. 2019, 72, 437–444. [Google Scholar] [CrossRef]
- Beer, B.; Bartolome, M.J.; Berndorfer, L.; Bochmann, G.; Guebitz, G.M.; Nyanhongo, G.S. Controlled Enzymatic Hydrolysis and Synthesis of Lignin Cross-Linked Chitosan Functional Hydrogels. Int. J. Biol. Macromol. 2020, 161, 1440–1446. [Google Scholar] [CrossRef] [PubMed]
- Srivastava, M.; Pandey, S.; Shahid, M.; Sharma, A.; Singh, A.; Kumar, V. Induction of Chitinase, -Glucanase, and Xylanase Taken from Trichoderma Sp. on Different Sources: A Review. Afr. J. Microbiol. Res. 2014, 8, 3131–3135. [Google Scholar] [CrossRef]
- Chen, L.; Yang, X.; Raza, W.; Li, J.; Liu, Y.; Qiu, M.; Zhang, F.; Shen, Q. Trichoderma harzianum SQR-T037 Rapidly Degrades Allelochemicals in Rhizospheres of Continuously Cropped Cucumbers. Appl. Microbiol. Biotechnol. 2011, 89, 1653–1663. [Google Scholar] [CrossRef]
- De León-Medina, J.C.; Buenrostro-Figueroa, J.J.; Sepúlveda, L.; Aguilar, C.N.; Ascacio-Valdés, J.A. Fungal Biodegradation of Ellagitannins Extracted from Rambutan Peel. Food Bioprod. Process. 2023, 141, 81–90. [Google Scholar] [CrossRef]
- He, X.; Wang, L.; Xia, B.; Cao, X.; Hu, N.; Huang, J.; Yi, Y. Antifungal Effect of Cinnamic Acid and Induced Resistance of Cinnamic Acid-Protocatechuic Acid-CaCl2-NaCl-Pullulan Composite Preservative to Trichoderma harzianum in Postharvest Hypsizygus Marmoreus. LWT 2023, 184, 115108. [Google Scholar] [CrossRef]
- Stanek, M.; Zubek, S.; Stefanowicz, A.M. Differences in Phenolics Produced by Invasive Quercus Rubra and Native Plant Communities Induced Changes in Soil Microbial Properties and Enzymatic Activity. For. Ecol. Manag. 2021, 482, 118901. [Google Scholar] [CrossRef]
- Maruyama, C.R.; Bilesky-José, N.; de Lima, R.; Fraceto, L.F. Encapsulation of Trichoderma harzianum Preserves Enzymatic Activity and Enhances the Potential for Biological Control. Front. Bioeng. 2020, 8, 225. [Google Scholar] [CrossRef]

| Parameters | Values |
|---|---|
| pH in KCl | 7.1 |
| C-org (%) | 1.18 |
| N-min (kg/ha) | 345 |
| N-NH4 (mg/kg) | 2.76 |
| N-NO3 (mg/kg) | 29.03 |
| P2O5 (mg/100 g) | 29 |
| Mg (mg/100 g) | 6.6 |
| K2O (mg/100 g) | 28 |
| Chitosan Films | Moisture Content (g/100 g) |
|---|---|
| CTS | 12.95 ± 1.61 |
| CTS-0.2%CA | 13.63 ± 2.19 * |
| CTS-0.4%CA | 16.24 ± 1.31 * |
| CTS-0.2%EA | 15.97 ± 3.24 * |
| CTS-0.4%EA | 13.17 ± 0.21 * |
| Isolates | Aminopeptidase | Lipase | Chitinase | α-Glucosidase | β-Glucosidase |
|---|---|---|---|---|---|
| T.01 | 11.58 ± 0.02 b | 36.75 ± 0.04 b | 19.91 ± 0.02 b | 2.91 ± 0.02 b | 4.01 ± 0.03 a |
| T.05 | 19.95 ± 0.01 a | 39.64 ± 0.03 b | 17.27 ± 0.03 b | 2.98 ± 0.07 b | 4.05 ± 0.1 a |
| T.07 | 20.15 ± 0.03 a | 55.78 ± 0.02 a | 43.03 ± 0.02 a | 4.18 ± 0.03 a | 4.09 ± 0.1 a |
| T.11 | 11.75 ± 0.01 b | 36.19 ± 0.03 b | 18.47 ± 0.02 b | 3.78 ± 0.04 a | 4.31 ± 0.06 a |
| T.14 | 12.45 ± 0.03 b | 62.21 ± 0.02 a | 41.27 ± 0.02 a | 4.11 ± 0.08 a | 4.09 ± 0.07 a |
| Chitosan Films | Isolates | ||||
|---|---|---|---|---|---|
| T.01 | T.05 | T.07 | T.11 | T.14 | |
| CTS | 0 | 0 | 106 ± 2.1 aA | 0 | 90 ± 2.2 bA |
| CTS-0.2%CA | 0 | 0 | 58 ± 1.3 aB | 0 | 35 ± 2.3 bB |
| CTS-0.4%CA | 0 | 0 | 18 ± 0.9 aC | 0 | 16 ± 3.1 aC |
| CTS-0.2%EA | 0 | 0 | 98 ± 2.1 aA | 0 | 88 ± 3.1 aA |
| CTS-0.4%EA | 0 | 0 | 47 ± 1.1 aB | 0 | 34 ± 2.1 aB |
| Chitosan Films | Variants | |||
|---|---|---|---|---|
| Native Soil Microorganisms | Isolate T.07 | Isolate T.14 | Consortium T.07 + T.14 | |
| CTS | 2189 ± 13.2 aA | 2884 ± 35.5 aA | 2675 ± 33.3 aA | 2929 ± 44.2 aA |
| CTS-0.2%CA | 1008 ± 23.3 bB | 1540 ± 33.1 aB | 1710 ± 14.2 aB | 1765 ± 23.3 aA |
| CTS-0.4%CA | 484 ± 12.9 cC | 611 ± 13.9 bD | 662 ± 12.8 bC | 917 ± 12.1 aC |
| CTS-0.2%EA | 1009 ± 24.5 bB | 1926 ± 14.4 aC | 1910 ± 13.1 aB | 1985 ± 22.9 aB |
| CTS-0.4%EA | 637 ± 14.1 bC | 1350 ± 13.3 aC | 1321 ± 14.5 aB | 1410 ± 12.2 aB |
| Variants | Enzyme Activity (U/h) | ||||
|---|---|---|---|---|---|
| Chitinase | Lipase | α-Glucosidase | β-Glucosidase | Aminopeptidase | |
| soil | 9.3 ± 0.13 c | 19.32 ± 0.14 a | 4.7 ± 0.11 a | 3.2 ± 0.11 a | 9.3 ± 0.16 a |
| CTS+soil | 16.2 ± 0.13 b | 21.5 ± 0.27 a | 4.3 ± 0.10 a | 3.5 ± 0.14 a | 10.1 ± 0.13 a |
| CTS+soil+T.07 | 27.3 ± 0.11 a | 11.7 ± 0.10 c | 4.6 ± 0.12 a | 3.8 ± 0.13 a | 9.8 ± 0.16 a |
| CTS+soil+T.14 | 25.5 ± 0.60 a | 22.2 ± 0.02 a | 5.5 ± 0.17 a | 2.0 ± 0.16 b | 10.1 ± 0.13 a |
| CTS+soil+consortium | 26.1 ± 0.23 a | 26.9 ± 0.03 a | 4.6 ± 0.41 a | 4.1 ± 0.13 a | 10.6 ± 0.03 a |
| CTS-0.2%CA+soil | 8.3 ± 0.11 c | 22.9 ± 0.03 a | 4.9 ± 0.13 a | 4.2 ± 0.13 a | 10.1 ± 0.13 a |
| CTS-0.2%CA+soil+T.07 | 24.3 ± 0.12 a | 17.8 ± 0.11 b | 5.3 ± 0.11 a | 4.8 ± 0.12 a | 10.1 ± 0.13 a |
| CTS-0.2%CA+soil+T.14 | 26.6 ± 0.17 a | 17.3 ± 0.06 b | 4.2 ± 0.11 a | 4.8 ± 0.12 a | 9.0 ± 0.14 a |
| CTS-0.2%CA+soil+consortium | 20.6 ± 0.22 b | 16.4 ± 0.11 b | 4.0 ± 0.14 a | 4.9 ± 0.11 a | 10.9 ± 0.11 a |
| CTS-0.4%C+soil | 8.9 ± 0.28 c | 19.9 ± 0.08 a | 4.7 ± 0.11 a | 4.2 ± 0.18 a | 6.7 ± 0.12 b |
| CTS-0.4%CA+soil+T.07 | 15.2 ± 0.11 b | 14.0 ± 0.04 b | 4.8 ± 0.11 a | 4.4 ± 0.11 a | 7.4 ± 0.13 b |
| CTS-0.4%CA+soil+T.14 | 18.3 ± 0.21 b | 23.3 ± 0.01 a | 4.6 ± 0.13 a | 4.9 ± 0.11 a | 6.5 ± 0.13 b |
| CTS-0.4%CA+soil+consortium | 18.5 ± 0.57 b | 25.1 ± 0.01 a | 4.3 ± 0.12 a | 4.6 ± 0.11 a | 6.1 ± 0.16 b |
| CTS-0.2%EA+soil | 9.8 ± 0.21 c | 21.3 ± 0.11 a | 4.8 ± 0.11 a | 5.1 ± 0.11 a | 9.7 ± 0.11 a |
| CTS-0.2%EA+soil+T.07 | 21.0 ± 0.22 a | 17.3 ± 0.10 b | 4.5 ± 0.20 a | 4.9 ± 0.10 a | 9.0 ± 0.12 a |
| CTS-0.2%EA+soil+T.14 | 20.1 ± 0.10 a | 20.0 ± 0.11 a | 4.4 ± 0.20 a | 5.0 ± 0.11 a | 8.1 ± 0.10 a |
| CTS-0.2%EA+soil+consortium | 19.5 ± 0.10 a | 17.6 ± 0.21 b | 4.2 ± 0.10 a | 4.6 ± 0.21 a | 10.2 ± 0.21 a |
| CTS-0.4%EA+soil | 8.2 ± 0.11 c | 16.8 ± 0.10 b | 4.1 ± 0.11 a | 3.0 ± 0.11 a | 4.3 ± 0.23 c |
| CTS-0.4%EA+soil+T.07 | 16.2 ± 0.10 b | 16.7 ± 0.20 b | 4.0 ± 0.12 a | 3.8 ± 0.10 a | 5.8 ± 0.21 b |
| CTS-0.4%EA+soil+T.14 | 17.3 ± 0.21 b | 17.5 ± 0.20 b | 4.1 ± 0.10 a | 3.3 ± 0.20 a | 6.3 ± 0.11 b |
| CTS-0.4%EA+soil+consortium | 16.6 ± 0.10 b | 16.0 ± 0.10 b | 4.0 ± 0.21 a | 3.7 ± 0.20 a | 5.5 ± 0.21 b |
| Symbols | Top-Hit Taxon | Top-Hit Strain | Similarity (%) | Completeness (%) |
|---|---|---|---|---|
| T.01 | Trichoderma atroviride | II ODh | 97.55 | 97 |
| T.05 | Trichoderma atroviride | MA3634 | 88.12 | 80 |
| T.07 | Trichoderma sp. | SDAS203127 | 94.29 | 96 |
| T.11 | Trichoderma hamatum | NECC30476 | 92.61 | 87 |
| T.14 | Trichoderma koningii | S54 | 94.32 | 98 |
Disclaimer/Publisher’s Note: The statements, opinions and data contained in all publications are solely those of the individual author(s) and contributor(s) and not of MDPI and/or the editor(s). MDPI and/or the editor(s) disclaim responsibility for any injury to people or property resulting from any ideas, methods, instructions or products referred to in the content. |
© 2024 by the authors. Licensee MDPI, Basel, Switzerland. This article is an open access article distributed under the terms and conditions of the Creative Commons Attribution (CC BY) license (https://creativecommons.org/licenses/by/4.0/).
Share and Cite
Swiontek Brzezinska, M.; Shinde, A.H.; Kaczmarek-Szczepańska, B.; Jankiewicz, U.; Urbaniak, J.; Boczkowski, S.; Zasada, L.; Ciesielska, M.; Dembińska, K.; Pałubicka, K.; et al. Biodegradability Study of Modified Chitosan Films with Cinnamic Acid and Ellagic Acid in Soil. Polymers 2024, 16, 574. https://doi.org/10.3390/polym16050574
Swiontek Brzezinska M, Shinde AH, Kaczmarek-Szczepańska B, Jankiewicz U, Urbaniak J, Boczkowski S, Zasada L, Ciesielska M, Dembińska K, Pałubicka K, et al. Biodegradability Study of Modified Chitosan Films with Cinnamic Acid and Ellagic Acid in Soil. Polymers. 2024; 16(5):574. https://doi.org/10.3390/polym16050574
Chicago/Turabian StyleSwiontek Brzezinska, Maria, Ambika H. Shinde, Beata Kaczmarek-Szczepańska, Urszula Jankiewicz, Joanna Urbaniak, Sławomir Boczkowski, Lidia Zasada, Magdalena Ciesielska, Katarzyna Dembińska, Krystyna Pałubicka, and et al. 2024. "Biodegradability Study of Modified Chitosan Films with Cinnamic Acid and Ellagic Acid in Soil" Polymers 16, no. 5: 574. https://doi.org/10.3390/polym16050574
APA StyleSwiontek Brzezinska, M., Shinde, A. H., Kaczmarek-Szczepańska, B., Jankiewicz, U., Urbaniak, J., Boczkowski, S., Zasada, L., Ciesielska, M., Dembińska, K., Pałubicka, K., & Michalska-Sionkowska, M. (2024). Biodegradability Study of Modified Chitosan Films with Cinnamic Acid and Ellagic Acid in Soil. Polymers, 16(5), 574. https://doi.org/10.3390/polym16050574







